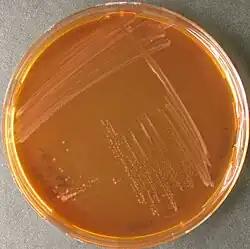

Nitriliruptor
| Nitriliruptor | ||
|---|---|---|
![]() | ||
| Taxonomía | ||
| Dominio: | Bacteria | |
| Reino: | Bacillati | |
| Filo: | Actinomycetota | |
| Clase: | Nitriliruptoria | |
| Orden: | Nitriliruptorales | |
| Familia: | Nitriliruptoraceae | |
| Género: |
Nitriliruptor Sorokin et al. 2009 | |
| Especie: | Nitriliruptor alkaliphilus | |
Nitriliruptor es un género de bacterias grampositivas de la familia Nitriliruptoraceae. Actualmente contiene una sola especie descrita: Nitriliruptor alkaliphilus. Fue descrito en el año 2009. Su etimología hace referencia a disrupción de nitrilo. El nombre de la especie hace referencia a amante del álcali.[1] Es aerobia e inmóvil. Es alcalífila obligada, con un pH de crecimiento entre 8,2-10,6, óptimo de 9-9,5. Tiene un tamaño de 0,4 μm de ancho por 1,5-3 μm de largo. Catalasa y oxidasa positivas. Forma colonias incoloras y planas. Temperatura de crecimiento óptima de 32 °C. Tiene un contenido de G+C de 70,8%. Se ha aislado de sedimentos de un lago alcalino en la estepa Kulunda, Rusia.
Referencias
- ↑ Sorokin, Dimitry Yu; van Pelt, Sander; Tourova, Tatjana P.; Evtushenko, Lyudmila I. (2009-02). «Nitriliruptor alkaliphilus gen. nov., sp. nov., a deep-lineage haloalkaliphilic actinobacterium from soda lakes capable of growth on aliphatic nitriles, and proposal of Nitriliruptoraceae fam. nov. and Nitriliruptorales ord. nov». International Journal of Systematic and Evolutionary Microbiology 59 (Pt 2): 248-253. ISSN 1466-5026. PMID 19196761. doi:10.1099/ijs.0.002204-0. Consultado el 17 de febrero de 2024.
